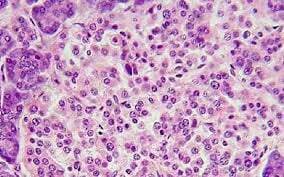
CENTRO DE ANATOMÍA PATOLÓGICA CITOLOGÍA EXFOLIATIVA COLPOSCOPIA Y ANDROSCOPIA Dr. Carlos Eduardo Taracena Baron-CÉLULAS

Nuestros servicios
Contacte al CENTRO DE ANATOMÍA PATOLÓGICA CITOLOGÍA EXFOLIATIVA COLPOSCOPÍA Y ANDROSCOPÍA DR ABRAHAM BARÓN ROJAS. FUNDADO EN 1970, el laboratorio de anatomía patológica de excelencia.
DIRECCIÓN
GRAL I ZARAGOZA, No. 705, PLANTA BAJA, CENTRO, VILLAHERMOSA, TABASCO. C.P. 86000
HORARIO
- Lun - Vie
- -
- Sábado
- -
- Domingo
- Cerrado
TELÉFONOS